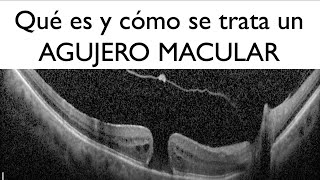

What are myodesopsias (floaters, floaters, or vitreous condensations) and how are they treated?

10:57
¿Qué es y cómo se trata la degeneración macular relacionada a la edad?

26:57
Floaters, floaters, floaters - My experience

15:41
Top 5 Reasons Patients REGRET Cataract Surgery, and How to Avoid Them
7:34
What is a macular hole and how is it treated? - Dr. Gerardo García Aguirre - Retina

15:34